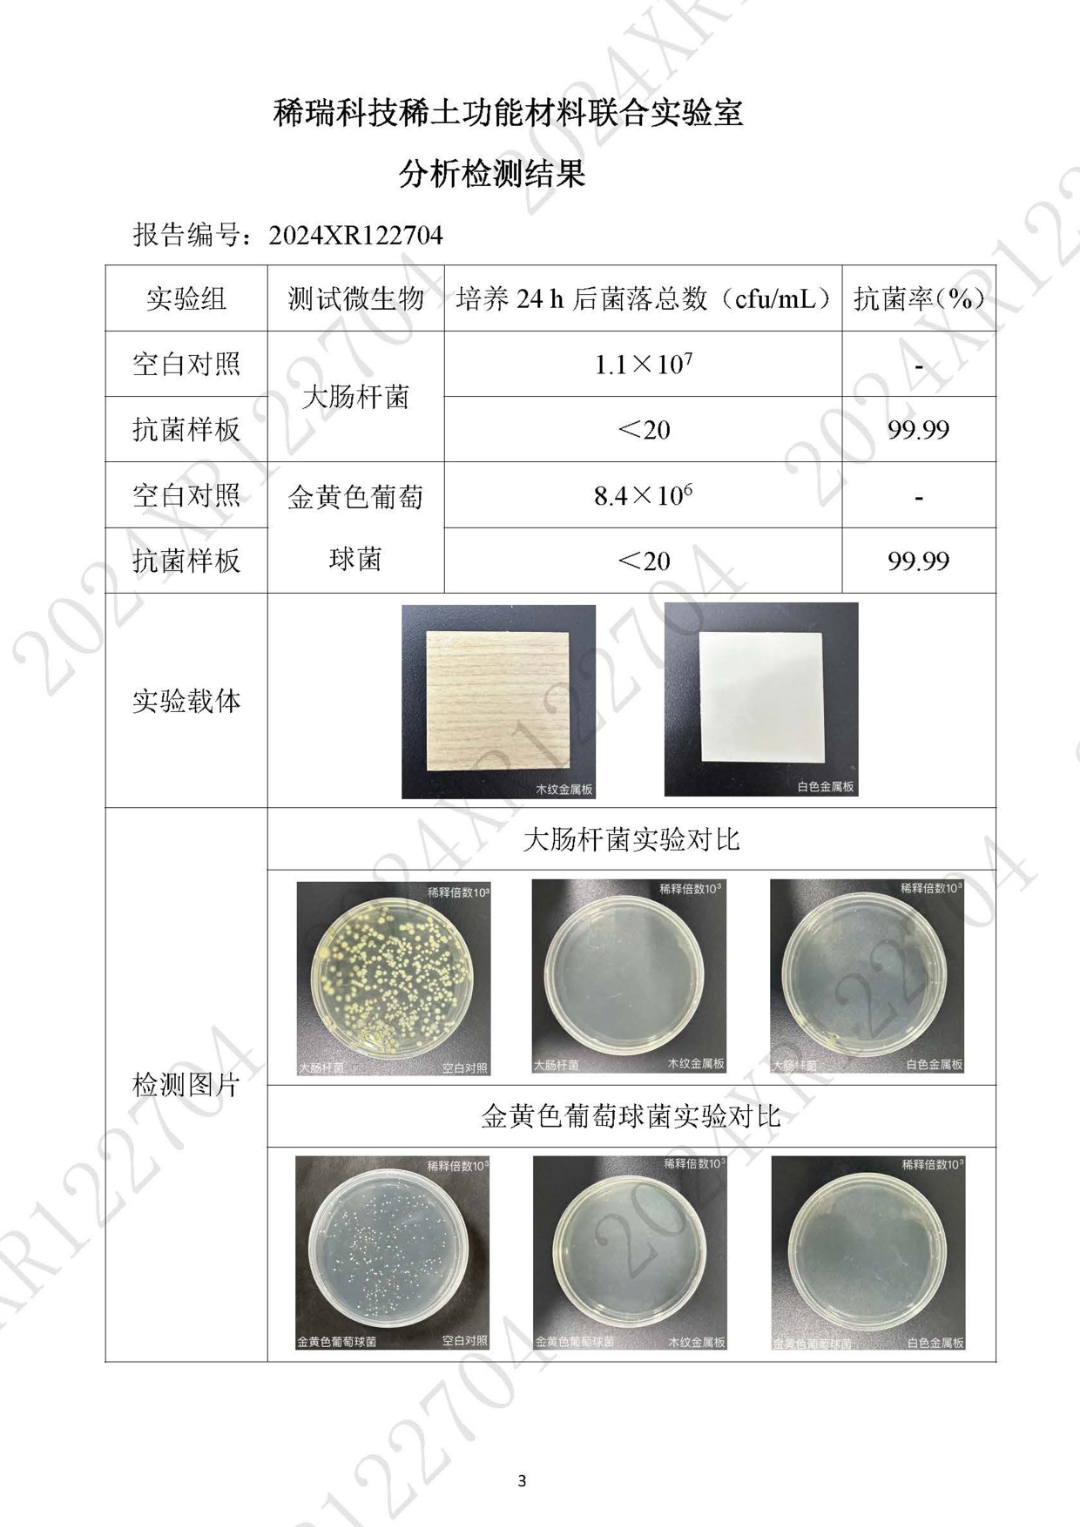

開物鑫動態,創新材料守護健康,歷時兩載功能如初
2025-01-10 15:51
15
杭州開物鑫工程技術有限公司(以下簡稱“開物鑫”)傾力參與的浙江大學醫學院附屬兒童醫院莫干山院區項目,自2022年底首批次供貨材料稀土抗菌抗病毒金屬板(白色、木紋系列)交付安裝,已達兩年。



兩年時光流轉,時間見證品質,近期,經過專業的取樣送檢程序,檢測結果顯示,該材料對大腸桿菌、金黃色葡萄球菌等病菌的抗菌抑制率依然高達99.99%!充分證明了其卓越且持久的抗菌抗病毒功能。
向右滑動查看更多 >>
這一結果體現了開物鑫在新材料技術領域的專業實力和創新能力,也彰顯了其在基礎設施領域對衛生、安全標準的極致追求,稀土抗菌抗病毒金屬板的應用,不僅為該項目健康環境增添了一道堅實屏障,持續守護醫護患兒的健康,還以其出色的耐用性與美觀度等特點,為醫院空間增添了品質與舒適感,實現了功能與美觀的完美融合。




以創新技術鑄就卓越品質,未來,開物鑫將繼續秉持高度的責任感和使命感,通過不斷探索新技術、新工藝的應用,以開放姿態引領創新,為更多領域提供健康、潔凈、高效的解決方案,滿足社會日益增長的多元化需求。



昵稱:
內容:
驗證碼: 
提交評論
評論一下